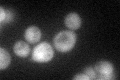
YJR025C
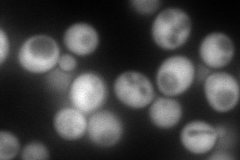
YJR025C
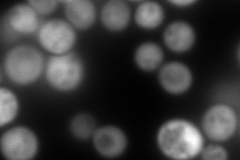
YJR025C
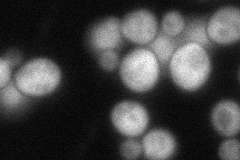
YJR025C
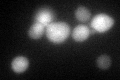
YJR025C
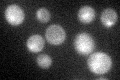
YJR025C

View description
3-hydroxyanthranilic acid dioxygenase, required for the de novo biosynthesis of NAD from tryptophan via kynurenine; expression regulated by Hst1p
Localization:
Intensity:
Fold change:
Significance:
-
C’ GFP library in SD
cytosol42.9 -
N' NOP1pr-GFP in SD
cytosol311.978 -
N' TEF2pr-mCherry in SD
cytosol524.106 -
N' NATIVEpr-GFP in SD
punctate71.8816 -
N' TEF2pr-VC and Cyto-VN in SD

#N/A0 -
C’ GFP library in SD+DTT
cytosol40.770.95No -
C’ GFP library in SD+H2O2

cytosol44.991.04No -
C’ GFP library in Starvation Media
cytosol39.810.92No -
C’ GFP library on the background of Pup2-DaMP

cytosol -
C’ GFP library on the background of CCT mutant

cytosol43.62211.01666No
